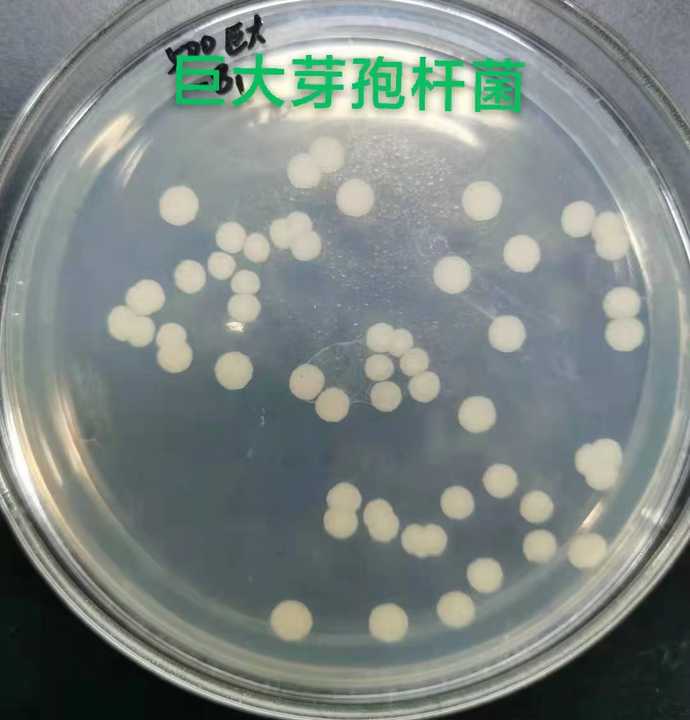

Product

Preview
Basic Info.Product Description
Basic Info.
CAS No. | // |
Purity | 10 billion |
Place of Origin | Shandong, China |
Classification | Biological Fertilizer |
Other Names | probiotics |
MF | /// |
EINECS No. | None |
Release Type | Controlled |
State | Powder |
Application | Biocontrol for plant dieases |
Brand Name | YiHao |
Model Number | YH-Agri-04 |
Product name | bacillus megatherium |
Appearance | Brown Powder |
Package | 25 Kg/bag |
Storage | Cool Dry Place |
Function | Plant Health |
MOQ | 1kg |
Sample | Availabe |
Service | 24 HOURS ONLINE SERVICE |
Certificate | ISO |
Brand | YiHao |
Packaging Details | bag&drum |
Port | qingdao port |
Supply Ability | 10000 Ton/Tons per Year |
Product Description
ProductDescription

Preview

Preview
Bacillusmegaterium
Bacillusmegateriumisoneofthestrainscommonlyusedintheproductionofbio-organicfertilizer.Ithasagoodeffectofdegradingorganophosphorusinsoil,andcanbeusedtoproducephosphorusandnitrogenfixingfertilizer.Ithasthecharacteristicsoffastreproduction,strongvitality,safetyandnon-toxic..
[ProductFeatures]
1.Environmentallyfriendly:non-toxictohumansandanimals,pollution-freetotheenvironment,andsafetocrops;
2.Highefficiencyandbroadspectrum:Ithasexcellentcontroleffectonavarietyofsoil-bornediseasescausedbyharmfulbacteriaandfungi.
3.Increaseproductionandimprovequality:itcansecreteavarietyofactivesubstancestopromotecropgrowth,makecropleavesthickandgreen,improvecropimmunity,increaseproductionandimprovequalityeffectissignificant,thefermentationprocessproducesavarietyofaminoacids,hasagrowthregulationeffectoncrops.
[Productefficacy]
1.Dissolvesineffectivephosphorusfromsoilandconvertsitintophosphorusthatcropscanuse.Thepolysaccharidessecretedbyitcanmakethesoilaggregatestructurebetter.
2.Sprayingoncropscanpromotecropgrowth,enhancephotosynthesisofplantleaves,increasecarbohydratecontenttoimprovequality;
3.Improvetheeffectiveuseofnutrientsinthesoil,improverootgrowthandnutrientabsorption,strengthentheresistanceofcropstoadverseenvironments,andreducetheapplicationofpesticides;Preventsoildiseases,reducecontinuouscroppingobstaclesandotherproblemstoachievetheeffectofsoilimprovement;
4.Makethecropcellwallthickening,fibrosis,lignificationdegree;Andformacolloidalsiliconlayeroutsidetheepidermallayer,formabarriertopreventbacteria,reducedisease;
[Productappearance]
Physicalproperties:brownpowderwithslightfermentationodor
Mainingredients:Bacillusgigantiumlivebacteriaanditsmetabolites
[Storagemethod]
Storeinacool,dryplace
[ProductSpecification]
Bacterialcount:20billionCFU/g,50billionCFU/g,100billionCFU/g
Packingspecification:1kg/bag,25kgs/bag
[Usageanddosage]
1.Additinorganicfertilizer,mixitwithorganicfertilizeraccordingtotheadditionamountof1000g~3000g/ton,anduseitasbasefertilizer,applyingitinholes.
2.useasbacterialagent,theamountofuseperacreis25~30grams,theusercanadjusttheamountaccordingtothespecificsituation.
3.ItcanbeusedtofermentorganicfertilizerwithBacillussubtilis,andtherecommendeddosageis0.01%~0.05%.
[Note]
1.Donotusewithfungicides,antibiotics,disinfectants;
2.Storeinacoolplaceawayfromlight,avoidstronglightexposure;
3.Theproductsthathavenotbeenusedupafteropeningshouldbesealedintime.
[TechnicalService]
SHANDONGYIHAOBIOTECHNOLOGYCO.,LTDcanhelpourvaluedcustomerstousethisproductdirectly!
Ourmissionistechnology,biologicalandenvironmentallyfriendly!
Bacillusmegateriumisoneofthestrainscommonlyusedintheproductionofbio-organicfertilizer.Ithasagoodeffectofdegradingorganophosphorusinsoil,andcanbeusedtoproducephosphorusandnitrogenfixingfertilizer.Ithasthecharacteristicsoffastreproduction,strongvitality,safetyandnon-toxic..
[ProductFeatures]
1.Environmentallyfriendly:non-toxictohumansandanimals,pollution-freetotheenvironment,andsafetocrops;
2.Highefficiencyandbroadspectrum:Ithasexcellentcontroleffectonavarietyofsoil-bornediseasescausedbyharmfulbacteriaandfungi.
3.Increaseproductionandimprovequality:itcansecreteavarietyofactivesubstancestopromotecropgrowth,makecropleavesthickandgreen,improvecropimmunity,increaseproductionandimprovequalityeffectissignificant,thefermentationprocessproducesavarietyofaminoacids,hasagrowthregulationeffectoncrops.
[Productefficacy]
1.Dissolvesineffectivephosphorusfromsoilandconvertsitintophosphorusthatcropscanuse.Thepolysaccharidessecretedbyitcanmakethesoilaggregatestructurebetter.
2.Sprayingoncropscanpromotecropgrowth,enhancephotosynthesisofplantleaves,increasecarbohydratecontenttoimprovequality;
3.Improvetheeffectiveuseofnutrientsinthesoil,improverootgrowthandnutrientabsorption,strengthentheresistanceofcropstoadverseenvironments,andreducetheapplicationofpesticides;Preventsoildiseases,reducecontinuouscroppingobstaclesandotherproblemstoachievetheeffectofsoilimprovement;
4.Makethecropcellwallthickening,fibrosis,lignificationdegree;Andformacolloidalsiliconlayeroutsidetheepidermallayer,formabarriertopreventbacteria,reducedisease;
[Productappearance]
Physicalproperties:brownpowderwithslightfermentationodor
Mainingredients:Bacillusgigantiumlivebacteriaanditsmetabolites
[Storagemethod]
Storeinacool,dryplace
[ProductSpecification]
Bacterialcount:20billionCFU/g,50billionCFU/g,100billionCFU/g
Packingspecification:1kg/bag,25kgs/bag
[Usageanddosage]
1.Additinorganicfertilizer,mixitwithorganicfertilizeraccordingtotheadditionamountof1000g~3000g/ton,anduseitasbasefertilizer,applyingitinholes.
2.useasbacterialagent,theamountofuseperacreis25~30grams,theusercanadjusttheamountaccordingtothespecificsituation.
3.ItcanbeusedtofermentorganicfertilizerwithBacillussubtilis,andtherecommendeddosageis0.01%~0.05%.
[Note]
1.Donotusewithfungicides,antibiotics,disinfectants;
2.Storeinacoolplaceawayfromlight,avoidstronglightexposure;
3.Theproductsthathavenotbeenusedupafteropeningshouldbesealedintime.
[TechnicalService]
SHANDONGYIHAOBIOTECHNOLOGYCO.,LTDcanhelpourvaluedcustomerstousethisproductdirectly!
Ourmissionistechnology,biologicalandenvironmentallyfriendly!
Packaging&Shipping

Preview

Preview

Preview

Preview

Preview

Preview
CompanyInformation

Preview

Preview
CERTIFICATION
OurServices

Preview
OURSERVICE
Factory Wholesale Improve Plant Resistance Release Phosphorus Biological Fertilizer Bacillus Megatherium For Plant
$3 ~ $3.5
Chemical industry chain · agricultural chemicals · Biological Fertilizer
global.BrandYiHao


50-99 EmployeesFood Manufacturing Industry